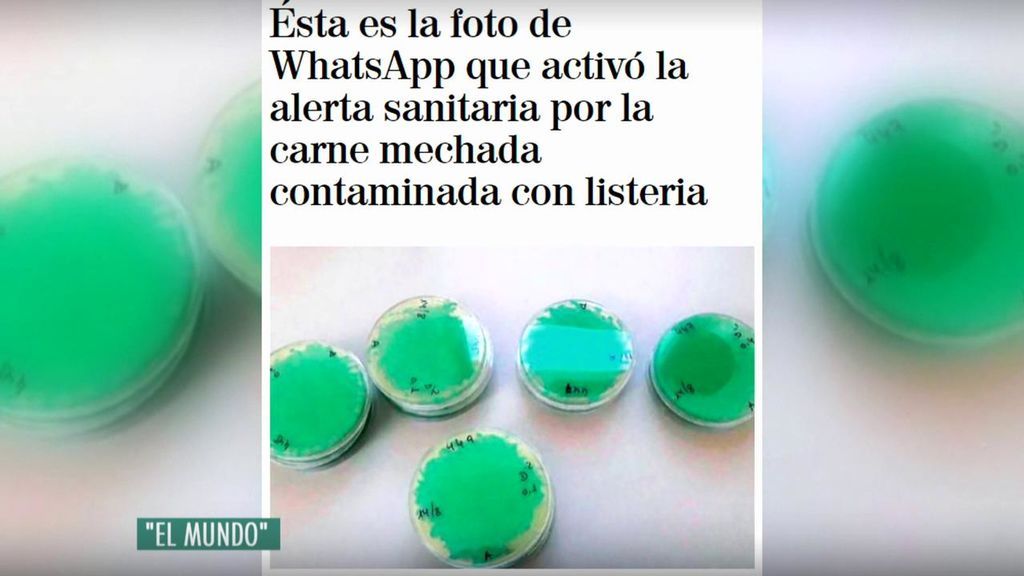
Listeriosis

El Ayuntamiento de Sevilla sospecha que Magrudis tiene otra fábrica no descubierta aún

Ya son cuatro los productos de Magrudis que han dado positivo en la positiva bacteria
La alerta sanitaria por listeriosis no para de crecer a otros productos de la empresa cárnica Magrudis. Ya son cuatro los productos de la empresa sevillana que han dado positivo en la peligrosa bacteria. A los ya conocido de carne mechada, lomo al jerez y lomo al pimentón se suma el producto de crema de carne mechada. La fábrica de Magrudis ya está precintada desde este fin de semana mientras se sigue investigando el origen del foco.
- María, una de las mujeres que ha perdido su bebe por listeriosis: “El mismo día que ingresé ya no había latidos en la eco”
- Cinco abortos por el brote de listeriosis que también causó la muerte del paciente de 71 años con cáncer
- Bajan a 61 los ingresados por listeria en Andalucía y se mantienen en 201 los casos confirmados
En total se han registrado 201 casos confirmados de listeriosis en España. La situación era grave cuando los responsables de Sanidad de la Junta recibieron por mensaje una llamativa imagen con el crecimiento de la bacteria de color verde en tan solo 48 horas. Las autoridades aseguran que el brote está focalizado solo en Sevilla aunque la polémica por la gestión sanitaria continúa.
